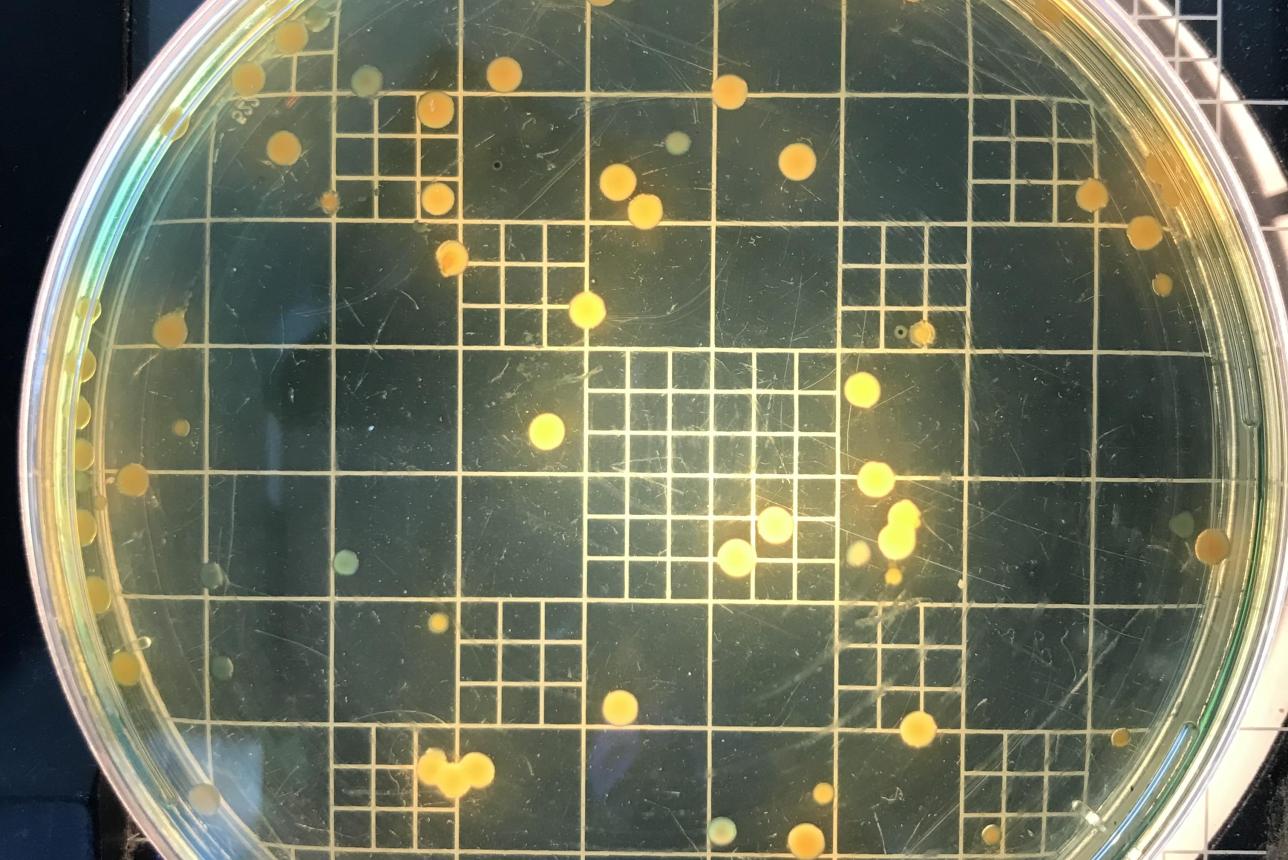
Close of up of vibrio bacteria

AquaDI
Advancing Aquatic Disease Science for a Healthier Environment

The mission of AquaDI is to provide robust science to guide effective management of diseases of aquatic resource species in waters of the Commonwealth and Chesapeake Bay region. Recent disease outbreaks have damaged economically important and ecologically sensitive marine resources in the Commonwealth and nation. Examples include mycobacteriosis in striped bass, dermo and MSX in oysters, Hematodinium in blue crabs, morbillivirus in dolphins, and wasting disease in sea stars, to name just a few.
By leveraging our expertise in shellfish and fish pathology, virology, bacteriology, parasitology, genetics and molecular biology, we are able to respond to current disease concerns and react to emerging disease threats.
Key Activities
- Pathology services for aquatic species
- Disease surveillance and diagnostic protocol development
- Outreach and graduate training
- Specialized research on mollusc, crustacean, eel, and fish diseases